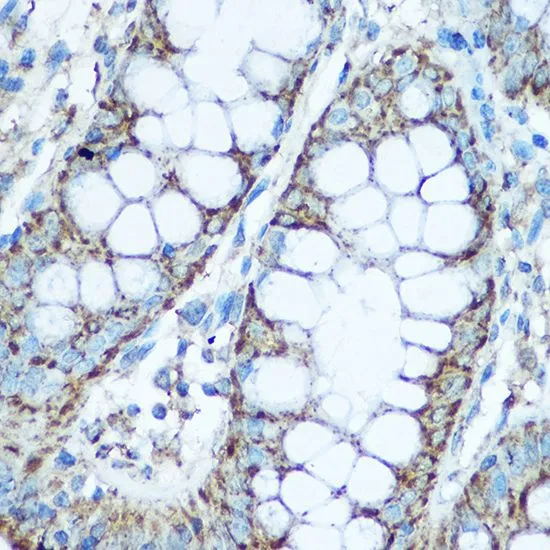

IP analysis of HepG2 cell lysate using GTX33573 UQCRC2 antibody. Antibody amount : 1microg / 200microg lysate Dilution : 1:1000
UQCRC2 antibody
GTX33573
ApplicationsImmunoPrecipitation, Western Blot, ImmunoHistoChemistry, ImmunoHistoChemistry Paraffin
Product group Antibodies
TargetUQCRC2
Overview
- SupplierGeneTex
- Product NameUQCRC2 antibody
- Delivery Days Customer9
- Application Supplier NoteWB: 1:500 - 1:2000. IHC-P: 1:50 - 1:100. IP: 1:50 - 1:200. *Optimal dilutions/concentrations should be determined by the researcher.Not tested in other applications.
- ApplicationsImmunoPrecipitation, Western Blot, ImmunoHistoChemistry, ImmunoHistoChemistry Paraffin
- CertificationResearch Use Only
- ClonalityPolyclonal
- ConjugateUnconjugated
- Gene ID7385
- Target nameUQCRC2
- Target descriptionubiquinol-cytochrome c reductase core protein 2
- Target synonymsMC3DN5, QCR2, UQCR2, cytochrome b-c1 complex subunit 2, mitochondrial, complex III subunit 2, cytochrome bc-1 complex core protein II, ubiquinol-cytochrome c reductase core protein II, ubiquinol-cytochrome-c reductase complex core protein 2
- HostRabbit
- IsotypeIgG
- Protein IDP22695
- Protein NameCytochrome b-c1 complex subunit 2, mitochondrial
- Scientific DescriptionThe protein encoded by this gene is located in the mitochondrion, where it is part of the ubiquinol-cytochrome c reductase complex (also known as complex III). This complex constitutes a part of the mitochondrial respiratory chain. Defects in this gene are a cause of mitochondrial complex III deficiency nuclear type 5. [provided by RefSeq, Jul 2015]
- Storage Instruction-20°C or -80°C,2°C to 8°C
- UNSPSC12352203